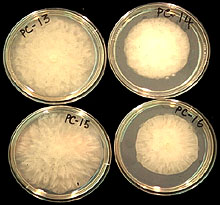

Mohammad Babadoost
University of Illinois
Department of Crop Sciences
AW-101 Turner Hall
1102 S. Goodwin Ave.
Urbana, IL 61801
Email: babadoos@uiuc.edu
Babadoost, M. 2004.Phytophthora Blight: A Serious Threat to Cucurbit Industries. APSnet Features. Online. doi:10.1094/APSnetFeature-2004-0404.

Introduction
Phytophthora blight, caused by the oomycete Phytophthora capsici, has become one of the most serious threats to production of cucurbits and peppers, both in the United States and worldwide (2,6,8,9,11,17,18,22,27,30). Phytophthora capsici was first described by Leonian on pepper in New Mexico in 1922 (20). In 1931, Tucker (38) classified it as a species of the genus Phytophthora and considered P. capsici as a host-specific fungus pathogenic on pepper. Subsequently, taxonomists (23,36,37) studied Phytophthora isolates from various hosts in the world and re-described the taxonomy of P. capsici.
Recently, the incidence of Phytophthora blight on cucurbits has dramatically increased in Illinois (2,32) and other cucurbit-growing areas in the world (8,9,17,18), causing up to 100% yield loss. Cucurbit industries, particularly processing industries, are seriously threatened by heavy crop loss resulting from Phytophthora blight. For example, outbreaks of Phytophthora blight have threatened the processing pumpkin and other cucurbit industries in Illinois, where 90% of processing pumpkins produced in the US are grown (2,3) (Figs. 1 and 2). Similarly, the pickling cucumber industry of Michigan is jeopardized by the increased occurrence of Phytophthora blight (8). Because of heavy crop losses the growers often have to abandon their own farms for cucurbit production and move into different areas, sometimes traveling more than 50 miles, to find fields not infested with P. capsici.
 |
|
 |
|
Fig. 1. A processing pumpkin field (and pumpkins, inset) at harvest in Illinois. |
|
Fig. 2. A cucurbit fruit showcase at a farm in Illinois. |
At present, no single method provides adequate control of P. capsici on cucurbits. No cucurbit cultivar with measurable resistance is available. In addition, crop rotation is virtually ineffective because the pathogen can survive for several years in the soil (8,40), and it can infect more than 50 plant species, including several weed species (6,32). Research is clearly needed to develop effective strategies for the management of Phytophthora blight caused by P. capsici on cucurbits and other vegetables.
Geographical Distribution
Phytophthora capsici on cucurbits was first reported in 1937 in Colorado and California (15,33). Since then Phytophthora blight has been observed in cucurbit growing areas throughout the world (4,5,6,7,40). Phytophthora capsici infection commonly occurs in temperate, subtropical, and tropical environments.
Host Range
In 1996, Erwin and Ribeiro (6) reported that 49 plant species can be infected by P. capsici. Among the major hosts are red and green peppers (Capsicum annuum), watermelon (Citrullum lanatus), cantaloupe (Cucumis melo), honeydew melon (C. melo), cucumber (Cucumis sativus), blue Hubbard squash (Cucurbita maxima), acorn squash (Cucurbita moschata), gourd (C. moschata), processing pumpkin (C. moschata), yellow squash (Cucurbita pepo), (C. pepo), zucchini squash (C. pepo), tomato (Lycopersicon esculentum ), black pepper (Piper nigrum ), and eggplant (Solanum melongena ). In 2004, Tian and Babadoost (32) reported five crop species/varieties -- beet (Beta vulgaris), Swiss chard (Beta vulgaris var. cicla), lima beans (Phaseolus lunatus), turnip (Brassica rapa), and spinach (Spinacia olerace) -- and one weed species, velvetleaf (Abutilon theophrasti), as hosts of P. capsici for the first time.
Symptoms and Signs
Phytophthora capsici can strike cucurbit plants at any stage of growth. The infection usually appears first in low areas of the fields where the soil remains wet for longer periods of time (Fig. 3A). The pathogen infects seedlings, vines, leaves, and fruit (Fig. 4).
Fig. 3. Post-emergence damping-off of pumpkin seedlings:
(A) a low area in a pumpkin field with severe seedling death; (B) damping-off of a seedling.
Fig. 4. Phytophthora blight symptoms on cucurbits:
(A) post-emergence damping-off of a pumpkin seedling; (B) crown infection of a summer squash plant; (C) lesions on an immature processing pumpkin fruit; (D) fruit rot of watermelon.
Damping-off. Phytophthora capsici causes pre- and post-emergence damping-off in cucurbits in wet and warm (20 to 30°C) soil conditions (5,6,12,40) (Fig. 3). In seedlings, a watery rot develops in the hypocotyls at or near the soil line, resulting in plant death (Fig. 3B). Post-emergence seedling death is preceded by plant wilting. Mature plants show symptoms of crown rot (Fig. 4B). Initial symptoms include a sudden, permanent wilt of infected plants without a change in color (40) (Fig. 5). The wilt of leaves progresses from the base to the extremities of the vines. Often plants die within a few days of the first appearance of symptoms or after the soil is saturated by excessive rain or irrigation. The stem near the soil line turns light to dark brown and becomes soft and water-soaked. Infected stems collapse and die. Tap and lateral roots of infected processing pumpkin plants usually do not exhibit any symptoms. Following death of the foliage, roots may give rise to new vines if environmental conditions become less conducive for disease development. Phytophthora damping-off may result in partial to total loss of the crop.
|

Fig. 5. Wilt of a pumpkin plant as a result of crown infection with P. capsici. |
|
Vine blight. Vines can be affected at any time during the growing season (2,6,40). Water-soaked lesions develop on vines (Fig. 6). The lesions are dark olive in the beginning (Fig. 6A) and become dark brown in a few days (Fig. 6B). The lesions girdle the stem, resulting in rapid collapse and death of foliage above the lesion site (Figs. 6C, 6D, and 7). Unaffected parts of the vine continue to grow if no girdling lesion develops along the vine.
Fig. 6. Vine symptoms of Phytophthora blight on pumpkin:
(A) lesions on a newly infected vine; (B) a fully-developed lesion;
(C) a girdling lesion affecting a part of a vine; (D) crown infection.
|

Fig. 7. Death of a muskmelon plant as a result of crown infection with P. capsici. |
|
Leaf symptoms. Phytophthora capsici can infect both the petiole and leaf blade (2,40). Dark brown, water-soaked lesions develop on petioles (similar to lesions on vines), resulting in a rapid collapse and death of leaves. Infection of the leaf blade results in development of leaf spots ranging from 5 mm to more than 5 cm in diameter (Fig. 8). Infected areas are chlorotic at first and then become necrotic with chlorotic to olive-green borders in a few days. Under wet and warm conditions, leaf spots expand rapidly, coalesce, and may cover the entire leaf. Under dry conditions, expansion of leaf spots may cease.
|

Fig. 8. Phytophthora spots, caused by P. capsici, on a pumpkin leaf. Note chlorosis and necrosis. |
|
Fruit rot. Fruit rot can occur from the time of fruit set until harvest (2,17,40) (Figs. 9 and 10). Fruit rot generally starts on the side of the fruit that is in contact with the soil (Fig. 9B). However, when an infected leaf or vine comes in contact with a fruit, fruit rot will start at the point of contact (Fig. 9C). Also, symptoms on the upper surface of the fruit develop following rain or overhead irrigation, which provides splashing water for pathogen dispersal. Fruit rot also can develop after harvest, during transit or in storage. Fruit rot typically begins as a water-soaked lesion (Fig. 9A), which expands, eventually covering the fruit with white mold (2,17) (Figs. 9 and 10). The pathogen produces numerous sporangia on infected fruit (Figs. 9 and 10). Fruit infection progresses rapidly, resulting in complete collapse of the fruit (Figs. 9D, 10C, and 10D). Phytophthora foliar blight and fruit rot may result in total loss of the crop (2).
Fig. 9. Fruit rot of processing pumpkin caused by P. capsici:
(A) a lesion on a fruit; (B) fruit rot developed on the side contacting the soil;
(C) fruit rot as a result of falling an infected leaf on fruit; (D) severely infected and collapsed fruit.
Fig. 10. Fruit rot caused by P. capsici on cucurbit crops in commercial fields in Illinois:
(A) cucumber; (B) jack-o-lantern pumpkin; (C) acorn squash; (D) zucchini.
Pathogen Identification
Identification of Phytophthora capsici is mainly based on the morphology of sporangia (6). Sporangia of P. capsici are variable in shape and are papillate with long pedicels (Fig. 11). Sporangial shapes are influenced by light and other cultural conditions, and are subspherical, ovoid, obovoid, ellipsoid, fusiform, and pyriform. Sporangia are tapered at the base and are caducous with long pedicels. Length × width of sporangia varies from 32.8 to 65.8 × 17.4 to 38.7 µm (6). Length/breath ratios of sporangia range from 1.3:1 to 2.1:1. Pedicel lengths are highly variable among the isolates, ranging from 35 to 138 µm.
|

Fig. 11. Sporangia and zoospores of P. capsici: (A) sporangia and zoospores; (B) a sporangium releasing zoospores. |
|
|
Fig. 12. Growth pattern of P. capsici colonies from processing pumpkin fields on lima bean agar, 5-day-old cultures. |
|
 |
|
 |
|
Fig. 13. Oospores of P. capsici. |
|
Fig. 14. An oospore of P. capsici with an amphigynous antheridium. |
Other characteristics of P. capsici isolates from cucurbits are: (i) colonies grow at temperatures from 10 to 36°C, with optimum temperatures of 24 to 33°C: (ii) growth patterns of colonies are cottony, petaloid, rosaceous, and stellate (Fig. 12); (iii) oospore diameters range from 22 to 34 µm (Fig. 13); and antheridia are amphigynous (Fig. 14). Phytophthora capsici is heterothallic, and both A1 and A2 types may exist in the same field.
Pathogenic and Genetic Diversity of P. capsici
Cucurbit isolates of P. capsici have been reported to be pathogenic on cucurbits, pepper, and tomato (12,15). Polach and Wenster (25) reported distinct pathogenic strains among isolates of P. capsici from tomato, pepper and squash. In North Carolina, Ristaino (26) evaluated the relative virulence of isolates of P. capsici from cucumber and squash on pepper and found differences in virulence among the isolates. In Italy, Tamietti and Valentino (30) grouped P. capsici isolates into 13 classes depending on their ability to infect different plant species (pepper, tomato, eggplant, melon, squash, pea, and French bean). In South Korea, Lee, et al. (18) studied aggressiveness of P. capsici isolates from pepper and pumpkin on pumpkin cultivars and reported significant pathogen-host interactions. In Illinois, Tian and Babadoost (31) reported significant differences among isolates of P. capsici from different locations.
Genetic variation among P. capsici isolates has been reported in vegetable growing areas in the world (10,16,19,31). Different methods have been used to study the genetic variation of fungi (16, 21,28,34,35,39). Internal transcribed spacer (ITS) regions have been used to determine genetic differences among species of Phytophthora (28). Inter-simple sequence repeats (ISSR) amplification is a new technique that could rapidly differentiate closely related individuals within a fungal species (31,39). Amplified fragment-length polymorphism (AFLP) is a recently developed polymerase chain reaction (PCR) technique that provides genetic markers for fingerprinting, mapping, and studying genetic relationships among populations within fungal species (1). Tian and Babadoost (31) used ISSR and AFLP tests to determine genetic differences among isolates of P. capsici from Illinois (Fig. 15). They reported that cluster analysis separated the isolates into four distinct groups, representing four different locations from which they had been collected.
|

Fig. 15. Products of inter-simple sequence repeats (ISSR) test of P. capsici using
primer (GTC)7. Marker is a 1-kb ladder (Promega, Inc. Madison, WI).
|
Disease Cycle and Epidemiology
Phytophthora capsici is a soilborne pathogen and survives between crops as oospores in soil or mycelium in plant debris (6,8,24,40). An oospore is a thick-walled sexual spore (Figs. 13 and 14) and is formed when mycelia of two opposite mating types (A1 and A2) grow together. Oospores are resistant to desiccation, cold temperatures, and other extreme environmental conditions, and can survive in the soil, in the absence of a host plant, for many years (8,40). Oospores germinate and produce sporangia and zoospores (asexual spores) (Fig. 11). Zoospores are released in water (Fig. 11B) and are dispersed by irrigation or surface water. Zoospores are able to swim for several hours and infect plant tissues. Abundant sporangia are produced on infected tissues, particularly on affected fruit (Figs. 9 and 10), and dispersed by water or through the air. Sporangia can either germinate and infect host tissues directly, or they can release zoospores, which can then infect the plant. If the environmental conditions are conducive, the disease develops very rapidly.
Soil moisture conditions are important for disease development (8,40). Sporangia form when the soil is at field capacity and they release zoospores when soil is saturated. The disease is usually associated with heavy rainfall, excessive-irrigation, or poorly drained soil. Frequent irrigation increases the incidence of the disease.
Disease Management
No single method currently available provides adequate control of Phytophthora blight. A combination of measures should be practiced to reduce the damage caused by P. capsici on cucurbits (2,8,12,13,14,40). The most effective practice in controlling P. capsici is preventing the pathogen from being moved into a new field. The following practices can help to manage Phytophthora blight in cucurbit fields:
1. Select fields with no history of Phytophthora blight.
2. Select fields that did not have cucurbit, eggplant, pepper, or tomato for at least 3 years. No rotation period has been established for effective management of Phytophthora blight of cucurbits.
3. Select fields that are well isolated from fields infested with P. capsici.
4. Select well-drained fields, or do not plant the crop in the areas of the field which do not drain well.
5. Clean farm equipment of soil between fields.
6. Plant non-vining crops (i.e., summer squash) on dome-shaped raised beds (approximately 25 cm high).
7. Plant resistant varieties, if available.
8. Avoid excessive irrigation.
9. Do not irrigate from a pond that contains water drained from an infested field.
10. Do not work in wet fields.
11. Scout the field for the Phytophthora symptoms, especially after major rainfall, and particularly in low areas.
12. When symptoms are localized in a small area of the field, disk the area.
13. Discard infected fruit, but not in the field.
14. Do not save seed from a field where Phytophthora blight occurred.
15. Remove healthy fruit from the infested area as soon as possible and check them routinely.
16. Do not display fruit for sale in an area that is infested with P. capsici.
17. Apply effective fungicides, when recommended. Seed treatment with either mefenoxam (Apron XL LS at 0.42 ml per kg of seed) or metalaxyl (Allegiance FL at 0.98 ml per kg of seed) can protects seedlings of cucurbits until 5 weeks after sowing seed (3). Applications of dimethomorph (Acrobat 50WP at 448 g/ha) plus copper sulfate (i.e., Cuprofix Disperss at 2.25 kg/ha), at weekly interwals, can provide effective protection against foliar blight and fruit rot caused by P. capsici in cucurbit fields (13). Crop losses resulting from Phytophthora blight in cucurbit fields can be minimized by combining Apron 50WP seed-treatment with applications of Acrobat plus copper.
Conclusion
Phytophthora blight, caused by P. capsici, is and will continue to be a serious threat to cucurbit production in the US and worldwide. There are no cucurbit cultivars with measurable resistance to Phytophthora blight, the pathogen survives in soils for several years, and limited chemical control of the disease is available. New strategies for management of Phytophthora blight are essential. Along with cultural management strategies, research is needed to assess the possibilities of using induced resistance in plants, genetically modified cultivars, biocontrol agents, and eradicant fungicides for control of P. capsici in cucurbits and other crops.
Additional Resources
Phytophthora blight photos
from Cornell's Vegetable MD Online
Vegetable diseases
from U of Illinois' Dept. of Crop Sciences
Phytophthora Blight of Peppers and Cucurbits
from North Carolina Cooperative Extension Service
An Integrated Approach to Manage Phytophthora Blight on Michigan’s Vine Crops
PDF from Project GREEEN at Michigan State University
Phytophthora capsici Zoospore Infection of Pepper Fruit in Various Physical Environments
from the Oklahoma Academy of Science
Phytophthora capsici Kök Boðazý Çürüklüðü
Phytophthora Fruit Rot
from an APSnet Feature (American Phytopathological Society)
Identification & Management of Pumpkin Diseases
PDF from Purdue Cooperative Extension
Cucurbit Production in Florida
PDF from University of Florida's Institute of Food and Agricultural Sciences (IFAS)
Managing Phytophthora Blight in Cucurbit Crops from Country Folks Grower
Phytophthora Blight of Cucurbits
from the VISTA infobase of the University of Illinois
Literature Cited
1. Alonso, S., and Glenn, H. H. 1999. Modification of the AFLP protocol applied to honey bee DNA. Biotech. 26:706-709.
2. Babadoost, M. 2000. Outbreak of Phytophthora foliar blight and fruit rot in processing pumpkin fields in Illinois. Plant Dis. 84:1345.
3. Babadoost, M., and Islam, S. Z. 2003. Fungicide seed treatment effects on seedling damping-off of pumpkin caused by Phytophthora capsici. Plant Dis. 87:63-68.
4. C.M.I. 1985. C.M.I. description of pathogenic fungi and bacteria No. 836. Phytophthora capsici. CAB, Kew, England.
5. Erwin, D. C., Bartnicki-Garcia, S., and Tsao, P. H. 1995. Phytophthora: Its Biology, Taxonomy, and Pathology. American Phytopathological Society, St. Paul, MN.
6. Erwin, D. C., and Ribeiro, O. K. 1996. Phytophthora Diseases Worldwide. American Phytopathological Society, St. Paul, MN.
7. Farr, D. F., Bills, G. F., Chamuris, G. P., and Rossman, A. Y. 1995. Fungi on Plants and Plant Products in the United States. American Phytopathological Society, St. Paul, MN.
8. Hausbeck, M. 2004. Phytophthora lessens learned: Irrigation water and snap beans. The Vegetable Growers News 38:2829.
9. Holmes, G. J., Lancaster, M. E., Rodriguez, R. J., and Redman, R. S. 2001. Relative susceptibility of cucurbit and solanaceous drops to Phytophthora blight. Phytopathology 91:S39. Publication no. P-2001-0283-AMA.
10. Hwang, B. K., Arthur, W. A., and Heitefuss, R. 1991. Restriction fragment length polymorphisms of mitochondrial DNA among Phytophthora capsici isolates from pepper (Capsicum annuum). System. Appl. Micriobiol. 14:111-116.
11. Hwang, B. K., and Kim, C. H. 1995. Phytophthora blight of pepper and its control in Korea. Plant Dis. 79:221-227.
12. Islam, S. Z., and Babadoost, M. 2002. Effect of red-light treatment of seedlings of pepper, pumpkin, and tomato on the occurrence of Phytophthora damping-off. HortSci 37:678-681.
13. Islam, S. Z., and Babadoost, M. 2004. Evaluation of selected fungicides for control of Phytophthora blight of processing pumpkin, 2004. Fung. & Nemat. Tests 59:V129.
14. Johnston, S. A. 1982. Control of the crown rot phase of Phytophthora blight of bell pepper with fungicides. Fung. & Nemat. Tests 37:73.
15. Kreutzer, W. A., Bodine, E. W., and Durrell, L. W. 1940. Cucurbit diseases and rot of tomato fruit caused by Phytophthora capsici. Phytopathology 30:972-976.
16. Lamour, K. H., and Hausbeck, M. K. 2002. The Spatiotemporal genetic structure of Phytophthora capsici in Michigan and implications for disease management. Phytopathology 92:681-684.
17. Latin, R. X., and Rane, K. 1999. Identification and Management of Pumpkin Diseases. BP-17, Purdue University, Lafayette, IN.
18. Lee, B. K., Kim, B. S., Chang, S. W., and Hwany, B. K. 2001. Aggressiveness of isolates of Phytophthora capsici from pumpkin and pepper. Plant Dis. 85:797-800.
19. Lee, S. B., White, T. J., and Taylor, J. W. 1993. Detection of Phytophthora species by oligonucleotide hybridization to amplified ribosomal DNA spacers. Phytopathology 83:177-181.
20. Leonian, L. H. 1922. Stem and fruit blight of pepper caused by Phytophthora capsici. Phytopathology 12:401-408.
21. Majer, D. R., Mithen, B.G., Lewis, P. V., and Oliver, R. P. 1996. The use of AFLP fingerprinting for the detection of genetic variation in fungi. Mycol. Res. 100:1107-1111.
22. Matheron, M. E., and Matejka, J. C. 1995. Comparative activities of sodium tetrathiocarbonate and metalaxyl on Phytophthora capsici and root and crown rot on chile pepper. Plant Disease 79:56-59.
23. Mchau, G. R. A., and Coffey, M. D. 1995. Evidence for the existence of two distinct subpopulations in Phytophthora capsici and a redescription of the species. Mycol. Res. 99:89-102.
24. Papavizas, G. S., Bowers, J. H., and Johnston, S. A. 1981. Selective isolation of Phytophthora capsici from soils. Phytopathology 71:129-133.
25. Polach, F. J., and Wenster, R. K. 1972. Identification of strains and inheritance of pathogencity in P. capsici. Phytopathology 62:20-26.
26. Ristaino, J. B. 1990. Interspecific variation among isolates of Phytophthora capsici from pepper and cucurbit fields in North Carolina. Phytopathology 80:1253-1259.
27. Ristaino, J. B., and Johnston, S. B. 1999. Ecologically-based approaches to management of Phytophthora blight on bell pepper. Plant Dis. 83:1080-1089.
28. Ristaino, J. B., Trout, C. L., and Gregory, P. 1998. PCR amplification of ribosomal DNA for species identification in the plant pathogen genus Phytophthora. Appl. Environ. Microbiol. 64:948-954.
29. Schmitthenner, A. F., and Hilty, J. W. 1962. A modified dilution technique for obtaining single-spore isolates of fungi from contaminated material. Phytopathology 52:582-583.
30. Tamietti, G. and Valentino, D. 2001. Physiological characterization of a population of Phytophthora capsici Leon. from northern Italy. J. Plant Pathol. 83:1101.
31. Tian, D., and Babadoost, M. 2003. Genetic variation among isolates of Phytophthora capsici from Illinois. Phytopathology 93:S84. Publication no. P-2003-0613-AMA.
32. Tian, D., and Babadoost, M. 2004. Host range of Phytophthora capsici from pumpkin and Pathogenicity of isolates. Plant Dis. 88:485-489.
33. Tompkin, C. M., and Tucker, C. M. 1937. Phytophthora root rot of honeydew melon. J. Agric. Res. 54:933-944.
34. Tooley, P. W., Bunyard, B. A., Carras, M. M., and Hatziloukas, E. 1997. Development of PCR primers from internal transcribed spacer region II for detection of Phytophthora species infecting potatoes. Appl. Environ. Microbiol. 63:1467-1475.
35. Trout, C. I., Ristaino, J. B., Madritch, M., and Wangsoomboondee, T. 1997. Rapid detection of Phytophthora infestans in late blight infected potatoes and tomatoes using PCR. Plant Dis. 81:1042-1048.
36. Tsao, P. H. 1991. The identities, nomenclature and taxonomy of Phytophthora isolates from black pepper. Pages 185-211 in: Diseases of Black Pepper. Proc. Int. Pepper Comm. Workshop on Black Pepper Diseases. Goa, India. Y.R. Sarma and T. Premkumar, eds.
37. Tsao, P. H., and Alizadeh, A. 1988. Recent advances in the taxonomy and nomenclature of the so-called “Phytophthora palmivora” MF4 occurring on cocoa and other tropical crops. Pages 441-445 in: 10th Int. Cocoa Res. Conf. Proc. Santo Domingo.
38. Tucker, C. M. 1931. Taxonomy of the genus Phytophthora deBary. Univ. MO. Agric. Exp. Stn. Res. Bull. 153.
39. White, T. J., Bruns, T., Lee, S., and Taylor, J. 1990. Amplification and direct sequencing of fungal ribosomal RNA genes for phylogenetics. Pages 315-322 in: PCR protocols: a guide to methods and applications. M. A. Innis, D.H. Gelfand, J.J. Sninsky, and T.J. White, ed. Academic Press, Inc., New York, N.Y.
40. Zitter, T. A., Hopkins, D. L., and Thomas, C. E. 1996. Compendium of Cucurbit Diseases. American Phytopathological Society, St. Paul, MN.
